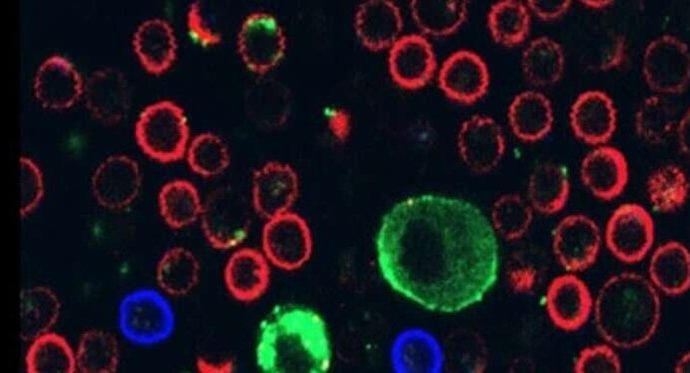
Un estudio liderado por la Universidad de Tel Aviv descubre un truco mortal del melanoma

Un equipo científico internacional, liderado por la Universidad de Tel Aviv, descubrió uno de los “trucos” más efectivos del melanoma, el cáncer de piel más agresivo y mortífero: un mecanismo que le permite desactivar a las células del sistema inmunológico encargadas de atacarlo.
El hallazgo no sólo ayuda a entender mejor cómo actúa la enfermedad, sino que también abre nuevas posibilidades para poder enfrentarla.
El descubrimiento surgió de un nuevo estudio que identificó cómo las células del melanoma logran paralizar a las defensas del organismo mediante la secreción de vesículas extracelulares, contenedores diminutos con forma de burbuja que cumplen un rol clave en la comunicación entre células.
Los investigadores consideran que este mecanismo tiene implicancias de largo alcance para el desarrollo de tratamientos contra la forma más letal de cáncer de piel.
Un esfuerzo científico internacional
El trabajo fue liderado por la profesora Carmit Levy, del Departamento de Genética Humana y Bioquímica de la Universidad de Tel Aviv, y contó con la colaboración de equipos de investigación del Hospital Sheba, el Instituto Weizmann, la Universidad de Lieja y el Technion.
También participaron expertos del Hospital Ijilov, el Centro Médico Wolfson, el Massachusetts General Hospital, el Centro Médico Hadassah, la Universidad Hebrea de Jerusalén, el Hospital Rabin, la Universidad Paris-Saclay y la Universidad de Zurich.
El melanoma, recordó el informe sobre la investigación (cuyos resultados fueron publicados en la revista científica Cell), es el tipo de tumor cutáneo más mortal.
En su primera etapa, las células melanocíticas se dividen de manera descontrolada en la epidermis, la capa externa de la piel. En la segunda, las células cancerosas invaden la dermis interna y comienzan a diseminarse a través de los sistemas linfático y sanguíneo, dando lugar a metástasis.
Foto: Levy, abajo a la derecha, junto a su equipo de investigadores (Foto: Universidad de Tel Aviv)
Cómo el melanoma neutraliza al sistema inmunológico
A partir de estudios previos, Levy había descubierto que, mientras crecen en la epidermis, las células del melanoma secretan grandes vesículas extracelulares llamadas melanosomas. Esas estructuras pueden penetrar los vasos sanguíneos y las células de la dermis, creando un entorno favorable —un “nicho”— que facilita su propagación.
Ahora, el nuevo estudio reveló que esas mismas vesículas cumplen además otra función crítica: permiten al tumor neutralizar a las células del sistema inmunológico que intentan atacarlo.
Cuando estudiaron esas vesículas, explicó Levy, notaron que en su membrana “había un ligando, una molécula que se supone que se une a un receptor que se encuentra únicamente en las células inmunológicas llamadas linfocitos, específicamente aquellos capaces de matar células cancerosas cuando entran en contacto directo con ellas”.
A partir de esa observación, la investigadora formuló la hipótesis de que ese ligando podía adherirse a los linfocitos que llegaban para atacar al melanoma.
“Era una idea innovadora y poco convencional”, reconoció Levy, pero comenzaron a desarrollarla en el laboratorio. A medida que se acumulaban las evidencias que respaldaban esta hipótesis, la investigadora contactó a colegas de distintos centros del mundo e invitó a sumar sus conocimientos y capacidades al proyecto.
Un logro “enorme”
La investigadora remarcó que “el logro es enorme”, ya que pudieron descubrir que este cáncer, “en esencia, dispara estas vesículas contra las células inmunológicas que lo atacan, interrumpiendo su actividad e incluso provocando su muerte”. De este modo, el melanoma no sólo logra evadir al sistema inmunológico, sino que lo debilita activamente.
Levy aclaró que, si bien se trata de un avance prometedor, todavía queda mucho trabajo por delante antes de poder traducir este conocimiento en una nueva terapia. “Pero ya está claro que este descubrimiento puede tener implicancias terapéuticas de gran alcance”, declaró.
Según señalaron desde la Universidad de Tel Aviv, los resultados del estudio podrían permitir, por un lado, fortalecer a las células inmunológicas para que resistan el contraataque del melanoma y, por otro, bloquear las moléculas que permiten que las vesículas se adhieran a las células de defensa.
“De cualquiera de las dos maneras, este trabajo abre una nueva puerta hacia intervenciones inmunoterapéuticas más eficaces”, concluyó Levy.
(Israel económico)